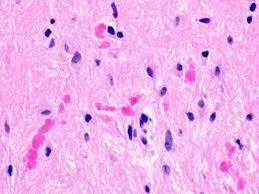
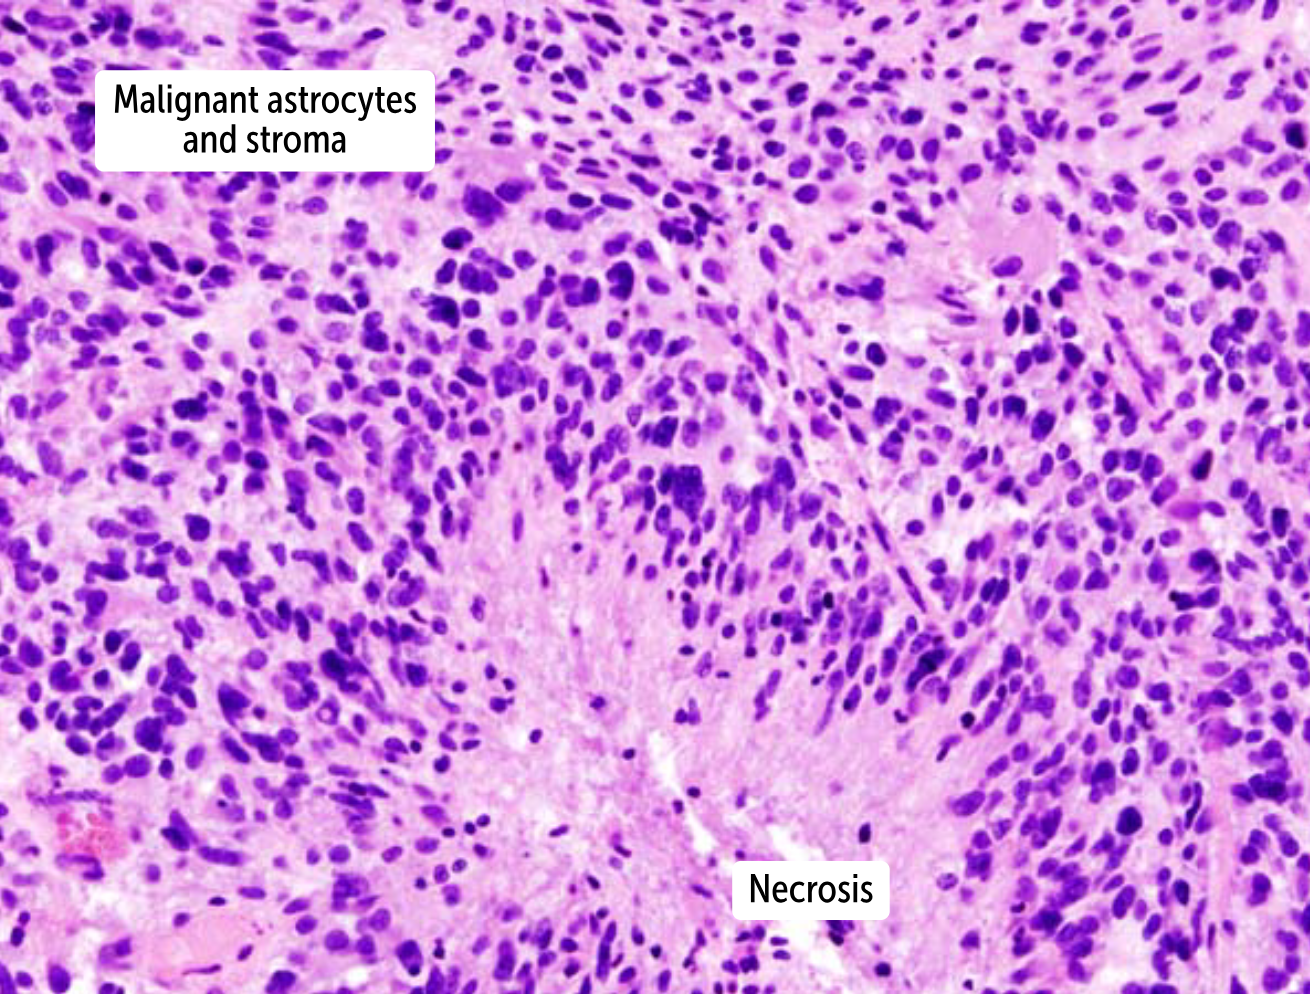

Histologic features of
Pilocytic astrocytoma
Biphasic
Rosenthal fibers [9c]
GFAP+ [9a]

Histologic features of
Infiltrating Astrocytoma
hypercellular
nuclear atypic
GFAP+
Histologic features of
Anaplastic astrocytoma
Hypercellular
nuclear atypic
GFAP+
**No microvascular proliferation of necrosis **
Bold is differentiator between this and an infiltrating astrocytoma
Histologic features of
Glioblastoma
Hypercellular
nuclear atypic
mitotic acitivity
GFAP+ [13f]
pseudo palisading necrosis [13e] sash
microvascular proliferation [13c] red hair beard moustache

Histological features of
Oligodendroglioma
“Fried egg” neuronal cell bodies (cytotoxic edema) [14e]
Chicken wire capillaries [14f]

Histologic features of
Ependymomas
Perivascular psuedorosettes [11f]
ependymal rosettes [11g]

Histologic features of
Meningiomas
Circumscribed [12d]
Spindle cells
Whorl pattern [12b]
Psammoma bodies [12f/18]

Histologic features of
Medullablastomas
Small roud cells
Homer-Wright rosettes [10i]

Histologic features of
Gangliogliomas
Binucleated ganglion cells
Peripheral Nissl substance
Glia
Calcifications
Glioma with WHO grade I
Pilocytic astrocytoma [9]

Glioma with WHO grade II
Infiltrating Astrocytoma
Oligodendroglioma [14]

Glioma with WHO grade III
Anaplastic Astrocytoma
Glioma with WHO grade IV
Glioblastoma [13]

Name this glioma
Pilocytic Astrocytoma [9c]

Name this glioma

Glioblastoma [13d]

Name this glioma
Glioblastoma [13e]

Name this glioma

Anaplastic Astrocytoma
Name this glioma

Oligodendroglioma [14e] [14f]

Name this glioma

Ependymoma [11]

Symptoms of
Pilocytic Astrocytoma
Cerebellar deficits [5] [6]

Symptoms of
Infiltrating Astrocytoma
New onset seizures
Symptoms of
Anaplastic Astrocytoma
New onset seizures
Headache
Focal signs
Symptoms of
Oligodenroglioma
Seizures [8]
Headache [10]
Focal signs [9]

Symptoms of
Ependymomas
Obstructive hydrocephalus [7]
Headache [2]
Vomiting [5]
Focal signs































